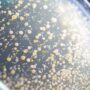

- Zoologia
- Storia e filosofia del mondo naturale
- Senza categoria
- Scienze
- Scienza e tecnologia cosmetica
- Psicologia
- Novità dal mondo scientifico
- Naturopatia
- Medicina
- Kids
- Integratori
- Fitoterapia
- Fitness
- Estetica
- Cosmetologia
- Cosmesi e psicologia
- Coaching
- Business
- Benessere
- Approfondimenti
- Ambiente e lifestyle
- Alimentazione
Glicazione della pelle: cos’è e come influisce sull’invecchiamento
Glicazione della pelle: cos’è, come accelera l’invecchiamento e le nuove ricerche scientifiche Negli ultimi anni, la ricerca cosmetica ha identificato nella glicazione cutanea uno dei principali meccanismi responsabili dell’invecchiamento della pelle. Non si tratta più solo di rughe causate dal sole o perdita di collagene: oggi sappiamo che anche gli zuccheri giocano un ruolo fondamentale […]
Scienziate che hanno cambiato la cosmetica
Scopri le scienziate che hanno rivoluzionato la cosmetica: innovazione, sicurezza e ricerca dietro i prodotti beauty moderni.
Scienzacosmetica propone dei corsi suddivisi per moduli tematici realizzati da docenti di diversa provenienza (aziendale, universitaria, consulenziale) per offrire un punto di vista multilaterale sugli argomenti trattati.
Opportunità
Corsi registrati e disponibili quando vuoi tu, attraverso la nostra piattaforma video.
Scienzacosmetica mette a disposizione i corsi di formazione in ambito cosmetico anche on demand.
I corsi sono registrati e disponibili quando vuoi tu, attraverso la nostra piattaforma video.
Sei interessata ad uno dei nostri corsi ma non hai potuto partecipare? Nessun problema! I corsi possono essere acquistati on demand e potrai vederli quando vuoi.
Consulenze
Ultimi articoli
ARTICOLI RECENTI
Le Nostre Partnership
Fitness
Aumento della massa muscolare, una delle finalità più ricercate dall’allenamento
Ciao, sono Fabio Mingirulli, e da personal trainer, cercherò di rispondere in maniera semplice a queste domande, che, da sempre, vengono poste a noi coach dai frequentatori di centri fitness.
Integratori
La fitoterapia: un alleato contro la stanchezza primaverile
La fitoterapia L’inverno è al termine e finalmente andiamo incontro alla primavera. Le giornate si allungano, le temperature aumentano…Tuttavia il cambio stagione porta con sé spossatezza, ansia e mancanza di concentrazione. Se un livello moderato di stress è salutare perché ci mantiene attivi, dei livelli troppo intensi (stress cronico) hanno effetti negativi sulla nostra qualità […]
scienze
Rallentare l’invecchiamento tramite l’attività fisica
La corsa all’aperto è un esempio di combinazione tra esercizio fisico e stimolazione cerebrale perché il cervello promuove la tenuta dell’equilibrio e l’orientamento oltre a scegliere il percorso migliore.